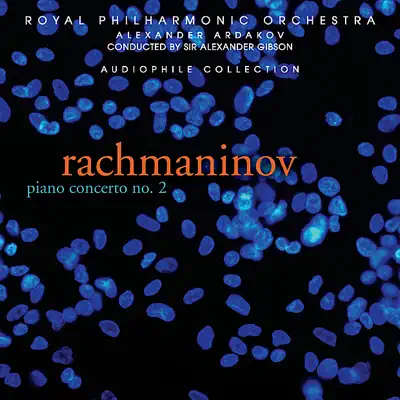

Rachmaninoff: Piano Concerto No. 2 In C Minor
- 1
Piano Conerto No. 2 In C Minor, Op. 18: I. Moderato
- 2
Piano Conerto No. 2 In C Minor, Op. 18: II. Adagio Sostenuto
- 3
Piano Conerto No. 2 In C Minor, Op. 18: III. Allegro Scherzando
2009 Royal Philharmonic Masterworks